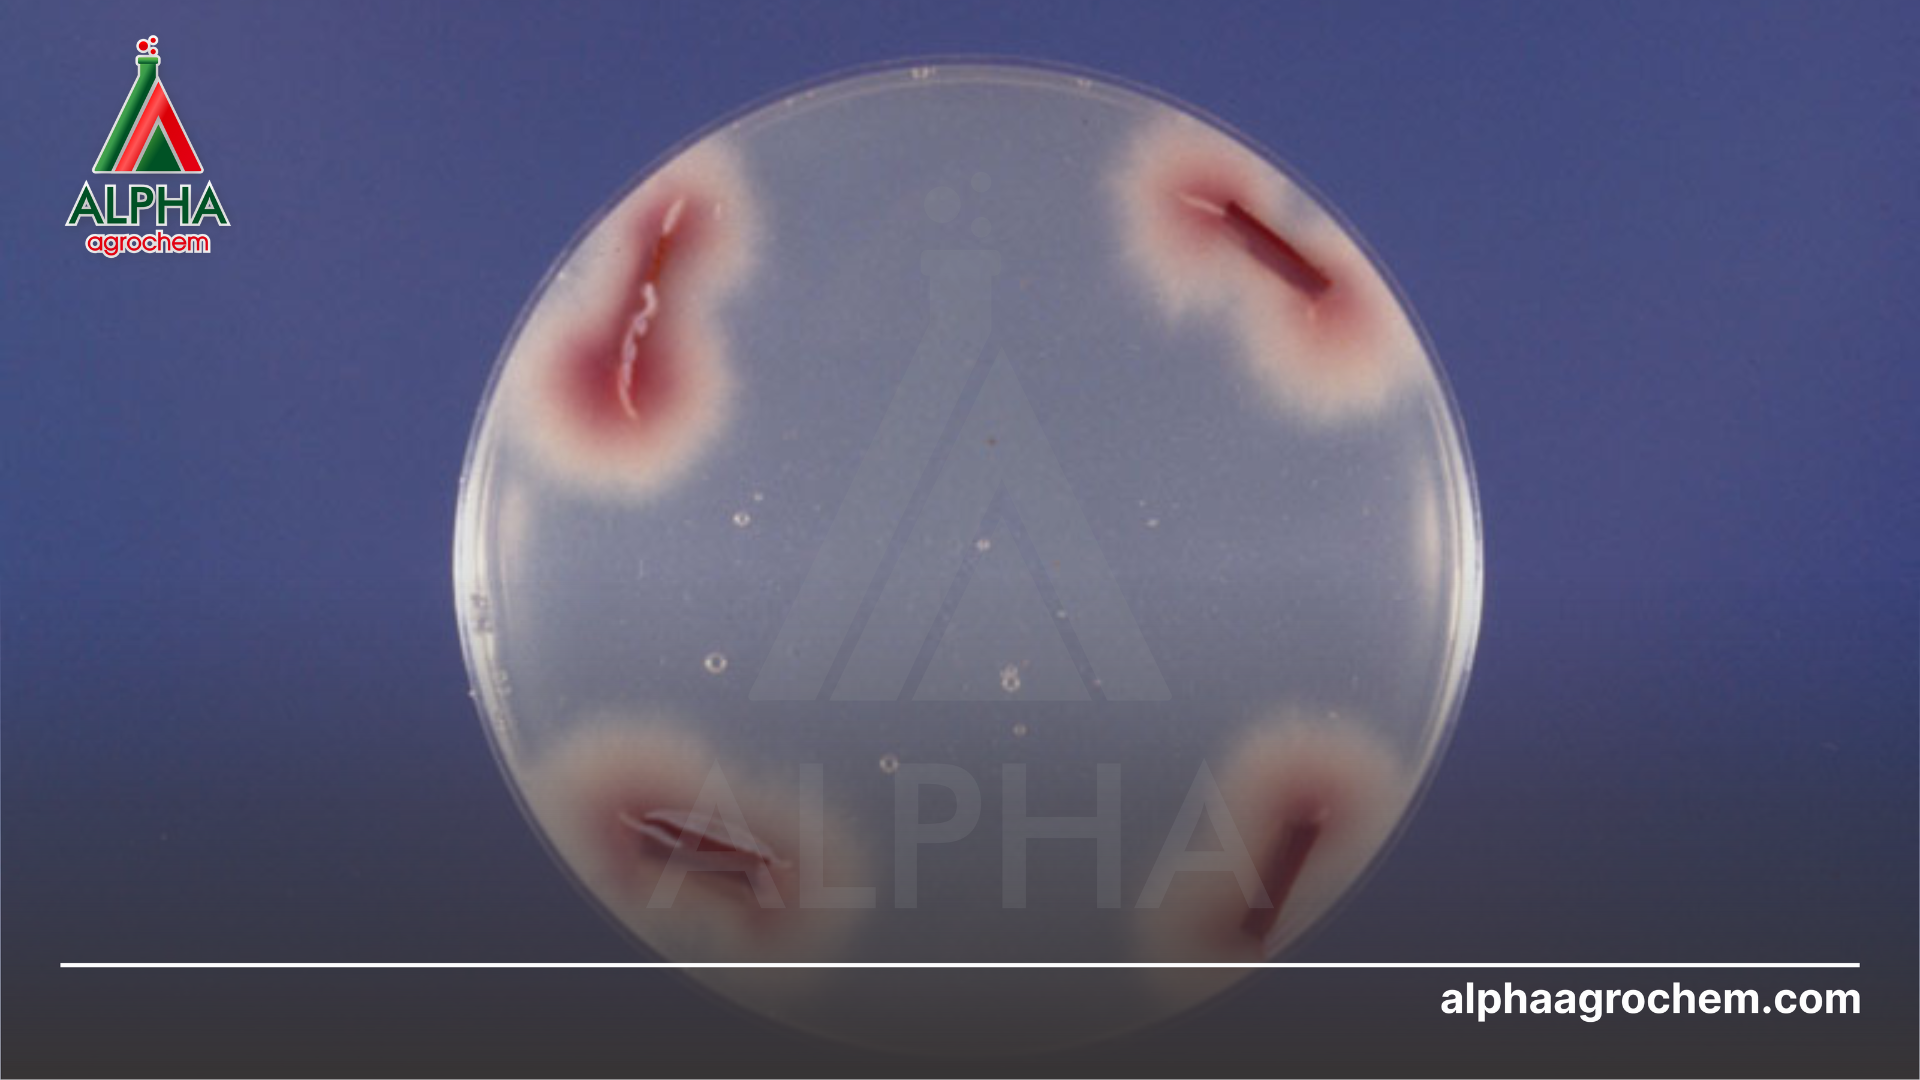
Nguyên nhân gây bệnh héo rũ

Héo rũ là gì – đây là bệnh hại phổ biến trên nhiều loại cây trồng, từ rau màu, cây công nghiệp đến cây ăn trái. Đặc trưng của bệnh là cây đang xanh tốt bỗng héo rũ dần, cuối cùng chết khô hàng loạt nếu không xử lý kịp. Bài viết này, Alpha Agrochem sẽ giúp bà con hiểu rõ héo rũ là gì, cách nhận biết, tác hại cũng như biện pháp phòng trừ hiệu quả để bảo vệ mùa vụ.
1. Nguyên nhân gây bệnh héo rũ trên hoa màu
Bệnh héo rũ trên hoa màu xuất phát từ nhiều tác nhân khác nhau. Chủ yếu là nấm, vi khuẩn và điều kiện môi trường bất lợi.
1.1. Nấm gây bệnh
– Fusarium oxysporum: Loại nấm phổ biến nhất gây héo rũ.
– Nấm tồn tại lâu trong đất, xâm nhập qua rễ bị tổn thương.
– Chúng gây tắc nghẽn mạch dẫn, khiến cây không hút được nước và dinh dưỡng.
– Verticillium spp.: Gây héo rũ tương tự Fusarium.
– Thường phát triển mạnh khi đất ẩm ướt và nhiệt độ cao.
1.2. Vi khuẩn gây bệnh
– Ralstonia solanacearum: Tác nhân chính gây bệnh héo xanh.
– Phổ biến trên cà chua, ớt, khoai tây và nhiều cây hoa màu khác.
– Vi khuẩn xâm nhập qua vết thương ở rễ, lan nhanh trong mạch dẫn
– Cây bị mất khả năng hấp thu nước, héo rũ nhanh chóng.
1.3. Điều kiện môi trường
– Đất thoát nước kém: Ngập úng lâu ngày làm rễ yếu, dễ nhiễm bệnh.
– Ẩm độ cao tạo điều kiện cho nấm và vi khuẩn phát triển.
– Nhiệt độ cao: Nắng nóng kéo dài khiến cây mất nước, suy yếu.
– Đây là yếu tố làm tăng nguy cơ bệnh héo rũ bùng phát.
2. Triệu chứng của bệnh héo rũ trên hoa màu
Triệu chứng bệnh héo rũ thường rất dễ nhận biết. Cây vẫn được tưới đủ nhưng lá và thân vẫn héo, không phục hồi.
2.1. Trên lá và thân cây
– Lá héo ban ngày: Ban đầu lá héo vào trưa, chiều tối tạm hồi.
– Lá vàng, nâu: Về sau lá héo hoàn toàn, đổi sang vàng hoặc nâu.
– Lá héo từ dưới lên: Ở nhiều cây, lá gốc héo trước rồi lan dần lên trên.
– Thân mềm yếu: Thân cây mất nước, mềm và héo úa.
– Thân đổi màu: Thân dần chuyển nâu, đen, khô héo từ gốc lên ngọn.
2.2. Trên rễ
– Rễ thối nâu đen: Rễ bệnh đổi màu, mất khả năng hút nước.
– Rễ nhỏ thối trước: Các rễ tơ, rễ nhỏ thường thối rữa đầu tiên.
– Lan sang rễ chính: Sau đó bệnh lan dần lên hệ rễ lớn.
– Tắc nghẽn mạch dẫn: Khi cắt ngang thân, thấy mạch nâu sẫm.
– Không vận chuyển dinh dưỡng: Cây mất khả năng hút và dẫn nước.
2.3. Trên quả
– Quả teo nhỏ: Cây có quả thường bị teo, phát triển kém.
– Quả rụng sớm: Do cây suy yếu, quả dễ rụng non.
– Hình dạng không đều: Quả méo mó, kém giá trị thương phẩm.
3. Tác hại của bệnh héo rũ
– Bệnh héo rũ gây ảnh hưởng nặng nề đến sản xuất hoa màu, đặc biệt trong các vụ mùa quan trọng.
– Giảm năng suất: Quang hợp và hút nước bị gián đoạn, cây sinh trưởng kém, nông sản giảm chất lượng.
– Mất mùa: Khi bệnh lây lan diện rộng, cây chết hàng loạt, nguy cơ mất trắng cả vụ.
– Thiệt hại kinh tế: Người trồng tốn thêm chi phí thuốc, phân và công chăm sóc, lợi nhuận giảm mạnh.

4. Biện pháp phòng trừ bệnh héo rũ
4.1. Biện pháp canh tác
– Luân canh cây trồng khác họ để cắt nguồn bệnh.
– Vệ sinh đồng ruộng, tiêu hủy tàn dư cây bệnh sau vụ thu hoạch.
– Trồng với mật độ vừa phải, vườn thông thoáng, đất thoát nước tốt.
– Bón phân cân đối, tránh thừa đạm, bổ sung hữu cơ hoai mục.
– Kết hợp nấm đối kháng Trichoderma ngay từ khâu làm đất.
4.2. Biện pháp sinh học
– Dùng chế phẩm sinh học chứa Trichoderma hoặc Bacillus subtilis để ức chế nấm bệnh.
– Sử dụng phân bón sinh học giúp rễ phát triển khỏe, tăng sức đề kháng.
– Kết hợp phân bón lá chứa vi lượng, giúp cây hồi phục nhanh hơn.
4.3. Biện pháp hóa học
– Phun phòng bằng thuốc gốc đồng, Mancozeb, Validamycin hoặc Kasugamycin.
– Khi bệnh xuất hiện, có thể dùng hoạt chất Metalaxyl, Copper Oxychloride, hoặc hỗn hợp Azoxystrobin + Difenoconazole.
– Luân phiên nhiều nhóm hoạt chất để tránh kháng thuốc.
– Tuân thủ thời gian cách ly, đảm bảo an toàn nông sản.
5. Câu hỏi thường gặp về bệnh héo rũ
1. Bệnh héo rũ thường xuất hiện trên cây nào?
→ Chủ yếu trên cà chua, ớt, khoai tây, dưa leo, lạc và nhiều cây hoa màu khác.
2. Héo rũ do nấm và vi khuẩn khác nhau thế nào?
→ Héo rũ nấm thường thấy mạch nâu trong thân, còn héo rũ vi khuẩn có dịch nhầy trắng đục.
3. Bệnh héo rũ có chữa khỏi hoàn toàn không?
→ Khó trị dứt điểm. Bà con cần kết hợp phòng bệnh tổng hợp từ đầu vụ để giảm thiệt hại.

Bệnh héo rũ là một trong những dịch hại nghiêm trọng, gây ảnh hưởng lớn đến năng suất và chất lượng hoa màu. Việc hiểu rõ héo rũ là gì, nguyên nhân, triệu chứng và tác hại sẽ giúp bà con chủ động hơn trong việc quản lý. Để bảo vệ mùa vụ, cần áp dụng đồng bộ các biện pháp: canh tác hợp lý, dùng chế phẩm sinh học, kết hợp thuốc hóa học khi cần thiết.
LIÊN HỆ TƯ VẤN MIỄN PHÍ
CÔNG TY TNHH HOÁ CHẤT NÔNG NGHIỆP ALPHA
ALPHA AGROCHEMICAL CO., LTD
Hotline: 0326 80 70 50
Địa chỉ: Số 153Q Trần Hưng Đạo, Phường An Phú, Quận Ninh Kiều, Thành phố Cần Thơ, Việt Nam
Website: alphaagrochem.com
Fanpage: facebook.com/alphaagrochem

